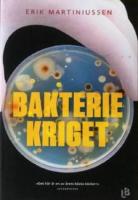
Bakteriekriget

-
Arkiv X oförklarliga fenomen. D. 1
Inbunden bok. Prisma. 1 uppl. 1996. 331 sidor.
Gott skick. Gallrat biblioteksexemplar. Något sliten rygg.
Inrikes enhetsfrakt Sverige: 62 SEK- ISBN
- 9789151831206
- Titel
- Arkiv X oförklarliga fenomen. D. 1
- Författare
- Jane Goldman
- Förlag
- Prisma
- Utgivningsår
- 1996
- Omfång
- 331 sidor
- Bandtyp
- Inbunden
- Vikt
- 1098 g
- Språk
- Svenska
Prisma 1 9789151831206 -
 Inrikes enhetsfrakt Sverige: 62 SEK
Inrikes enhetsfrakt Sverige: 62 SEK- ISBN
- 9789147053551
- Titel
- Näringslära för högskolan
- Författare
- Lillemor Abrahamsson - Agneta Andersson - Gerd Nilsson (red.)
- Förlag
- Liber
- Utgivningsår
- 2006
- Omfång
- 464 sidor
- Bandtyp
- Häftad
- Vikt
- 966 g
- Språk
- Svenska
- Baksidestext
- Näringslära för högskolan - från grundläggande till avancerad nutrition är ett svenskt standardverk inom utbildningar på högskolenivå, sedan 30 år tillbaka.
Läs mer
Boken (upplaga 6) presenterar bland annat:
- Näringsämnen, digestion, metabolism och behov
- Bioaktiva ämnen i kosten och nutritionsgenomik
- Hälsopåståenden om ämnen i livsmedel
- Kostrelaterade sjukdomar i Sverige och internationellt
- Matvanor, kostundersökningar och nutritionsstatusbestämning
- Idrottsnutrition
- Kostsociologi och modedieter
- Uppdaterade näringsrekommendationer
Förutom faktainformation innehåller boken många idéer som kan användas inom undervisning och nutritionsarbete. Boken vänder sig till universitets- och högskolestudenter inom näringslära, kost och hälsa samt till yrkesverksamma inom hälsoområdet, t.ex. lärare, dietister, nutritionister, läkare och sjuksköterskor. Den fungerar också utmärkt som innehållsrik uppslagsbok.
De 20 författarna är erfarna universitetslärare, nutritionister, dietister och forskare.
Om författarna
Lillemor Abrahamsson, f.d. universitetslektor, fil. dr, Institutionen för kostvetenskap, (f.d. Institutionen för hushållsvetenskap), Uppsala universitet.
Agneta Andersson, universitetslektor, docent, med. dr, leg. dietist, Institutionen för kostvetenskap, Uppsala universitet.
Gerd Nilsson, f.d. universitetslektor, Institutionen för kost- och idrottsvetenskap (f.d. Institutionen för hushållsvetenskap), Göteborgs universitet.
Liber 5 9789147053551 -
 Inrikes enhetsfrakt Sverige: 62 SEK
Inrikes enhetsfrakt Sverige: 62 SEK- ISBN
- 9789144039848
- Titel
- Evolutionsbiologi
- Författare
- Björklund, Mats
- Förlag
- Studentlitteratur AB
- Utgivningsår
- 2005
- Omfång
- 246 sidor
- Bandtyp
- Häftad
- Vikt
- 364 g
- Språk
- Svenska
- Baksidestext
- Boken börjar med en grundlig genomgång av den logiska uppbyggnaden av evolutionsteorin, och de tre faktorer som främst påverkar evolutionen, nämligen variation, ärftlighet och selektion. Boken ger en översiktlig bild av hur olika idéer runt evolution utformats före, samtidigt med och efter Darwin. Den innehåller dessutom kapitel om evolutionär utvecklingsbiologi, hur nya arter uppstår samt hur man kan spåra den evolutionära historien. I slutet finns ett kapitel om människans evolution samt hur kön och könsroller uppstått. En rad kontroversiella begrepp såsom genetisk determinism, slumpens roll, själviska gener och socialdarwinism tas upp. Boken vänder sig till alla som är intresserade av evolutionsteori i allmänhet och förutsätter inga bakgrundskunskaper i biologi.
Studentlitteratur AB 1 9789144039848 -

Ett sammanvävt liv : hur svamparna förenar vå...
Inbunden bok. Volante. 2021. 402 sidor.
Mycket gott skick. Skyddsomslag i gott skick.
Inrikes enhetsfrakt Sverige: 62 SEK- ISBN
- 9789189043596
- Titel
- Ett sammanvävt liv : hur svamparna förenar vår värld, förändrar våra sinnen och formar vår framtid
- Författare
- Sheldrake, Merlin
- Förlag
- Volante
- Utgivningsår
- 2021
- Omfång
- 402 sidor
- Bandtyp
- Inbunden
- Mått
- 145 x 225 mm Ryggbredd 33 mm
- Vikt
- 660 g
- Språk
- Svenska
- Baksidestext
- Anrika vetenskapsakademin Royal Societys pris för bästa populärvetenskapliga bok 2021.En livsform så märklig och förunderlig att den får dig att se livet på ett helt nytt sätt.
Hur kommer det sig att en japansk forskare kan påstå att en slemsvamp är smartare än människor? Och vad har det med IKEA att göra? Kan det verkligen stämma att den största kända svampen på jorden täcker en yta större än 10 kvadratkilometer? Och vad har bläcksvampar egentligen att göra med produktionen av den här boken? Varken växt eller djur, svampar finns överallt på jorden, i luften och i våra kroppar. De kan vara mikroskopiska och samtidigt är några av världens största organismer svampar 10 kvadratkilometer stora, 35 000 ton tunga och över 2 000 år gamla. Svampars förmåga att äta sten lade grunden för det första livet på land, och under 40 miljoner år var det väldiga formationer av svampar som dominerade världens yta. Svampar kan överleva i rymden och frodas i radioaktiv strålning. Svampar kan lösa problem utan någon hjärna och vidgar alla definitioner av intelligens. De kan manipulera djur på sätt som är så imponerande att vi ännu inte förstått fullt ut hur det går till. Upptäckten av hur svampar förenar växtlivet på planeten i ett massivt nätverk Wood Wide Web håller på att omforma hela vår syn på hur icke-animaliskt liv fungerar. Genom att ha gett människan bröd, alkohol och livräddande mediciner har svamparna omformat vår arts historia. Dess förmåga att förtära plast, sprängmedel, gifter och råolja har börjat användas i teknikens absoluta framkant. Svamparnas psykedeliska egenskaper, som påverkat kulturer sedan antiken, har nyligen visat sig bära på tänkbara lösningar på några av våra svåraste mentala sjukdomar. Och ändå har vi knappt kartlagt en bråkdel av de miljoner arter av svampar som lever på jorden. I sin omvälvande upptäcktsfärd tar Merlin Sheldrake oss med in i den spektakulära och okända värld som är svamparnas. Följ med och lär dig om organismerna som skapat vår värld och som är i fullt fart med att forma vår framtid.
Volante 9789189043596 -
 Inrikes enhetsfrakt Sverige: 62 SEK
Inrikes enhetsfrakt Sverige: 62 SEK -

Exit Jorden : om livets förutsättningar i rym...
Inbunden bok. Natur & Kultur Allmänlitteratur. 1 uppl. 2023. 285 sidor.
Mycket gott skick. Skyddsomslag i gott skick.
Inrikes enhetsfrakt Sverige: 62 SEK- ISBN
- 9789127179363
- Titel
- Exit Jorden : om livets förutsättningar i rymden
- Författare
- Ivarsson, Magnus
- Förlag
- Natur & Kultur Allmänlitteratur
- Utgivningsår
- 2023
- Omfång
- 285 sidor
- Bandtyp
- Inbunden
- Mått
- 140 x 215 mm Ryggbredd 23 mm
- Vikt
- 464 g
- Språk
- Svenska
- Baksidestext
- Kan resor till Mars och utomjordiska kolonier bli verklighet inom en snar framtid eller är det bara science fiction? Och varför ska vi ens lämna vår kära hemplanet?
I Exit jorden beger vi oss ut på en rymdfärd med slutdestination Mars och grundandet av mänsklighetens första koloni. Vi lyfter blicken från de tekniska aspekterna av rymdfarten och tittar närmare på hur vi kan använda mikroorganismer för att producera mat, mediciner och byggnadsmateriel för att göra Mars mer lik jorden. Vi undersöker också hur människan med hjälp av bioteknik kan anpassa sig för ett liv i rymden och kanske på sikt utvecklas till en multiplanetär art som bebor ett flertal himlakroppar.
Vare sig utforskandet av rymden beror på en skenande klimatkris eller ekonomiska vinningar är det något djupt mänskligt att hela tiden sträva mot platser ingen tidigare besökt.
Natur & Kultur Allmänlitteratur 1 9789127179363 -
 Inrikes enhetsfrakt Sverige: 62 SEK
Inrikes enhetsfrakt Sverige: 62 SEK- ISBN
- 9789155211769
- Titel
- 1000 frågor & svar
- Författare
- Baxter, Nicola
- Förlag
- Bokförlaget Semic
- Utgivningsår
- 2003
- Omfång
- 192 sidor
- Bandtyp
- Häftad
- Mått
- 164 x 210 mm Ryggbredd 15 mm
- Vikt
- 511 g
- Språk
- Svenska
- Baksidestext
- 1000 FRÅGOR & SVAR är en behändig uppslagsbok som hjälper den vetgirige att hitta svaren på alla tänkbara frågor. Den är uppdelad i tre ämnesområden: Livet på jorden, Vetenskap och Hur saker och ting fungerar:Hur många olika sorters maskar finns det?Hur försvarar sig växtätare mot rovdjur?Vad är snabbast i universum? Hur kan en båt flyta? Vilka var först med att bygga vägar?Boken innehåller massor av bilder och teckningar i färg, hundratals fotografier, ritningar och kartor, ordförklaringar till varje avsnitt och ett omfattande register.
Bokförlaget Semic 9789155211769 -

Antarktis : okänd kontinent
Inbunden bok. Uppsala : Fyris. 1979.
Mycket gott skick. Skyddsomslag i mycket gott skick.
Inrikes enhetsfrakt Sverige: 62 SEK- ISBN
- 9789185356102
- Titel
- Antarktis : okänd kontinent
- Författare
- Bond, Creina - Siegfried, Roy - Johnson, Peter
- Förlag
- Uppsala : Fyris
- Utgivningsår
- 1979
- Språk
- Svenska
Uppsala : Fyris 9789185356102 -
 Inrikes enhetsfrakt Sverige: 62 SEKHarper & Row
Inrikes enhetsfrakt Sverige: 62 SEKHarper & Row -

TEFYMA - Handbok för grundläggande fysik, fys...
Inbunden bok. Sjöbergs förlag. 1 uppl. 1979.
Gott skick. Pärm i gott skick men trycket på pärmen slitet. Namnad och med anteckningar i inlagan.
Inrikes enhetsfrakt Sverige: 62 SEKSjöbergs förlag 1 -

Ädelstenar : med utförliga presentationer av...
Inbunden bok. Prisma. 1 uppl. 1995. 160 sidor.
Mycket gott skick. något slitage på hörnen.
Inrikes enhetsfrakt Sverige: 62 SEK- ISBN
- 9789151827766
- Titel
- Ädelstenar : med utförliga presentationer av de 130 vanligaste smyckestenarna
- Författare
- Cally Hall
- Förlag
- Prisma
- Utgivningsår
- 1995
- Omfång
- 160 sidor
- Bandtyp
- Inbunden
- Vikt
- 457 g
- Språk
- Svenska
Prisma 1 9789151827766 -

Så förråddes Anne Frank
Inbunden bok. HarperCollins Nordic. 1 uppl. 2022. 367 sidor.
Mycket gott skick. Skyddsomslag i mycket gott skick. Recex.
Inrikes enhetsfrakt Sverige: 62 SEK- ISBN
- 9789150967418
- Titel
- Så förråddes Anne Frank
- Författare
- Sullivan, Rosemary
- Förlag
- HarperCollins Nordic
- Utgivningsår
- 2022
- Omfång
- 367 sidor
- Bandtyp
- Inbunden
- Mått
- 145 x 216 mm Ryggbredd 29 mm
- Vikt
- 467 g
- Språk
- Svenska
- Baksidestext
- Frågan som gäckat miljontals läsare har nu fått ett svarÖver trettio miljoner människor har läst Anne Franks dagbok, skriven av en trettonårig flicka som gömde sig för nazisterna i två år – innan hon blev avslöjad och skickad till ett koncentrationsläger. Trots att hennes öde behandlats i böcker, filmer och pjäser har ingen tidigare slagit fast vem eller vad som gjorde att hon och hennes familj hittades av nazisterna.Nu - 75 år senare - vet vi svaret. Tack vare ny DNA-teknik, mer sofistikerade undersökningsmetoder och ett internationellt team, lett av tidigare FBI-agenten Vince Pankoke. Teamet har gått igenom tiotusentals dokument och intervjuat mängder av personer som på något sätt levde nära familjen Frank. Tillsammans har de lyckats återskapa dagarna som ledde fram till familjens arrestering och kommit fram till en ny slutsats. Deras arbete skildras här av författaren och poeten Rosemary Sullivan. Hon ger oss också en naken inblick i hur det var att leva i en ockuperad stad där du oberoende av hur rik, fattig, välutbildad eller försiktig du var, aldrig kunde vara säker på vem du kunde lita på."Rosemary Sullivans bok är väl värd att läsa, inte bara för att den rycker ut Anne Frank ur den profitalstrande pseudovärld som hennes öde sedan länge befinner sig i (...) och kastar oss tillbaka till andra världskrigets bistra verklighet, utan också för att den visar på hur energiskt lagarbete med modernast möjliga undersökningsmetoder kan resultera i nya insikter i vad som länge har uppfattats som ett cold case." Dick Harrison, Svenska Dagbladet"Rosemary Sullivan lyckas på en lättflytande prosa levandegöra kontexten kring familjen Frank, livet i ett splittrat Amsterdam där den sociala tilliten i varje ögonblick sätts på prov och gråzonerna är stora. Helhetsbetyg 5.", Katarina Tavakol, BTJ-häftetRosemary Sullivan har skrivit femton böcker, bland annat den flerfaldigt prisbelönade biografin Stalins dotter (på svenska 2016). Hon är professor emeritus vid universitetet i Toronto och har undervisat i Kanada, USA, Indien samt flera länder i Europa och Latinamerika.
HarperCollins Nordic 1 9789150967418 -
Inrikes enhetsfrakt Sverige: 62 SEK
Inrikes enhetsfrakt Sverige: 62 SEK- ISBN
- 9789177992226
- Titel
- Bakteriekriget
- Författare
- Martiniussen, Erik
- Förlag
- Louise Bäckelin Förlag
- Utgivningsår
- 2020
- Omfång
- 412 sidor
- Bandtyp
- Inbunden
- Mått
- 145 x 218 mm Ryggbredd 33 mm
- Vikt
- 582 g
- Språk
- Svenska
- Baksidestext
- Vi står inför den största hälsokatastrofen världen har skådat. Kan vi bekämpa den?Varje år dör 700 000 personer av antibiotikaresistenta bakterier världen över. I USA tar resistenta bakterier livet av tre gånger så många människor som HIV och AIDS. Världshälsoorganisationen varnar för att den medicinska vetenskapen kommer att återgå till vad den var för 100 år sedan utan antibiotika. Vi kommer att stå försvarslösa mot vanliga infektioner och enkla ingrepp blir omöjliga att utföra. Innan år 2050 kommer 10 miljoner människors liv att vara i fara varje år. Den största hälsokatastrofen världen har skådat står för vår tröskel, ändå är det knappt någon som talar om den. Bakteriekriget avslöjar det cheferna för läkemedelsindustrin, sjukhusen och köttindustrin inte vill att du ska veta. Det är chockerande uppgifter om hur jakten på vinst har drivit läkemedelsindustrin till att distribuera antibiotika som om det vore vitaminer, och om hur köttindustrin systematiskt undanhållit information om en omfattande användning av antibiotika inom lantbruket. Djur och bakterier har i hundratusentals år levt i en balans som den obegränsade konsumtionen av antibiotika nu hotar att sätta ur spel. Finns det något hopp kvar? Ett gammalt botemedel, bevarat av läkare och sjuksköterskor i Georgien, är på väg att återupptäckas och det kan komma att ändra den medicinska historien igen. ERIK MARTINIUSSEN är en norsk journalist och författare. Han har tidigare skrivit boken Drivhuseffekten."I boken presenteras spännande, skrämmande och även hoppingivande fakta i reportageform på ett lättläst sätt. Läsaren upplever sig betydligt kunnigare och mer rustad för tillvaron efter att ha plöjt de 400 sidorna. Boken rekommenderas en bred läsekrets." BTJ"Bakteriekriget är en högintressant och tankeväckande bok som fängslar från första till sista sidan! Utan tvekan är detta en av årets intressantaste böcker! Martiniussens reportagebok är initierad och väldokumenterad och fungerar som en ögonöppnare! Högsta betyg! 5 av 5." Minaboktips.se
Louise Bäckelin Förlag 9789177992226 -
 Inrikes enhetsfrakt Sverige: 62 SEK
Inrikes enhetsfrakt Sverige: 62 SEK- ISBN
- 9789189043718
- Titel
- Sant, falskt eller mittemellan?
- Författare
- Frans, Emma
- Förlag
- Volante
- Utgivningsår
- 2020
- Omfång
- 205 sidor
- Bandtyp
- Mått
- 111 x 180 mm Ryggbredd 13 mm
- Vikt
- 122 g
- Språk
- Svenska
- Baksidestext
- Dras myggor verkligen mer till vissa personer? Går det att bota bakfylla? Får folk som träffats på nätet sämre relationer? Är frukosten dagens viktigaste mål? Dör rockstjärnor verkligen tidigare än "normala" människor? I "Sant, falskt eller mittemellan" redogör Emma Frans för de vetenskapliga svaren på stora och små frågor om allt från hälsa till kärlek; som vanligt underhållande men ändå pedagogisk och korrekt. Och genom alla exemplen får läsaren ytterligare en lektion i vetenskapligt tänkande och hur trovärdiga och tillförlitliga olika forskningsmetoder verkligen är, samtidigt som en hel del myter bekräftas eller avfärdas. "Sant, falskt eller mittemellan" är boken för dig som vill bli smartare och dessutom få underhållande material till fika- eller middagsdiskussioner.--- Emma Frans är forskare på Karolinska institutet och vetenskapsskribent. Hon fick sitt stora genombrott med succéboken "Larmrapporten: att skilja vetenskap från trams" (som nu finns i pocket). Hon medverkar regelbundet i SVT och Svenska Dagbladet och är en mycket populär föreläsare. Hon har fått Stora journalistpriset och utsetts till Årets folkbildare.
Volante 9789189043718 -

Vad Einstein verkligen sagt
Häftad bok. Stockholm : Rabén & Sjögren. 1972.
Gott skick. Bucklig. Prislapp kvar på baksidan. Märken på ryggen.
Inrikes enhetsfrakt Sverige: 62 SEK- ISBN
- 9129451906
- Titel
- Vad Einstein verkligen sagt
- Författare
- Wagner, Josef
- Förlag
- Stockholm : Rabén & Sjögren
- Utgivningsår
- 1972
- Språk
- Svenska
Stockholm : Rabén & Sjögren 9129451906 -

Kroppen: Organ - Organsystem - Funktioner
Inbunden bok. Värdefullt Vetande.
ISBN 9783625120520
Gott skick. Baksidan av omslaget är lite buckligt.
Inrikes enhetsfrakt Sverige: 62 SEKVärdefullt Vetande 9783625120520 -

Jorden: Hav - Kontinenter - Universum
Inbunden bok. Värdefullt Vetande. 1 uppl. 2013. 96 sidor.
Mycket gott skick.
Inrikes enhetsfrakt Sverige: 62 SEK- ISBN
- 9783625120490
- Titel
- Jorden : hav, kontinenter, universum
- Förlag
- Stevali
- Utgivningsår
- 2013
- Omfång
- 96 sidor
- Bandtyp
- Inbunden
- Mått
- 237 x 293 mm Ryggbredd 12 mm
- Vikt
- 660 g
- Språk
- Svenska
- Baksidestext
- Hur uppstår jordbävningar? Varför blixtrar det och dundrar det vid åskväder? Vad är egentligen växthuseffekten? Vill du få svar på dessa och många andra frågor om Jorden och omvärlden? Följ då med på en spännande resa och lär dig mer om geologi, geografi och miljö: du får kunskap om Jordens inre uppbyggnad och om kontinentaldriften. Du får veta hur en orkan uppstår och vad tidvatten beror på. sakkunniga texter och över 150 bilder åskådliggör och redogör för de vetenskapliga sakförhållandena gällande jordens inre och dess ytstruktur samt atmosfären och dess uppbyggnad. Lättfattliga texter, mängder av foton, grafik och illustrationer. Lämplig för barn från 10 år.
Värdefullt Vetande 1 9783625120490 -

Dinosaurierna: Upptäckterna - Arterna - Under...
Inbunden bok. Värdefullt Vetande. 1 uppl. 2013. 96 sidor.
Mycket gott skick.
Inrikes enhetsfrakt Sverige: 62 SEK- ISBN
- 9783625120544
- Titel
- Dinosaurierna:Upptäckterna, arterna, undergången
- Förlag
- Stevali
- Utgivningsår
- 2013
- Omfång
- 96 sidor
- Bandtyp
- Inbunden
- Mått
- 237 x 294 mm Ryggbredd 14 mm
- Vikt
- 660 g
- Språk
- Svenska
- Baksidestext
- Vilka jätteödlor härskade under miljontals år över oceanerna och kontinenterna? Vad orsakade dinosauriernas, flygödlornas och havsreptilernas undergång? Vill du få svar på dessa och många andra frågor om livet under urtiden? Följ då med på en spännande resa i dinosauriernas värld: du får reda på hur livet på Jorden utvecklades och lär dig mer om dinosaurierna och deras förfäders utseende. Betrakta ett skelett av en Tyrannosaurus - träd in dinosauriernas värld och lär dig mer om till exempel Brachiosaurus, Spinosaurus och Triceratops. Sakkunniga texter och över 150 bilder åskådliggör och redogör för de viktigaste typerna och deras livsmiljöer - allt från stora köttätare såsom Allosaurus till mindre av typen Velociraptor. Lättfattliga texter, mängder av foton, grafik och illustrationer. Lämplig för barn från 10 år.
Värdefullt Vetande 1 9783625120544 -

Universum: Stjärnsystem - Planeter - Galaxer
Inbunden bok. Värdefullt Vetande.
ISBN 9783625120506
Mycket gott skick.
Inrikes enhetsfrakt Sverige: 62 SEKVärdefullt Vetande 9783625120506 -

101 fakta om vetenskap
Inbunden bok. Barthelson Förlag. 2016. 127 sidor.
Mycket gott skick. Några hundöron i boken.
Inrikes enhetsfrakt Sverige: 62 SEK- ISBN
- 9781785996016
- Titel
- 101 fakta om vetenskap
- Författare
- Regan, Lisa
- Förlag
- Barthelson Förlag
- Utgivningsår
- 2016
- Omfång
- 127 sidor
- Bandtyp
- Kartonnage
- Mått
- 190 x 255 mm Ryggbredd 16 mm
- Vikt
- 600 g
- Språk
- Svenska
- Baksidestext
- Med den här boken får barnen lära sig en massa saker om vetenskapens fantastiska värld. Boken innehåller 101 tankeväckande och ovanliga fakta, den täcker allt, från dinosaurier och matsmältning till protoner och periodiska system. Alla fakta relaterar till viktiga ämnen inom kemi, fysik eller biologi på ett sätt som gör dessa lätta att förstå och roliga att läsa om.
Barthelson Förlag 9781785996016 -

Med barnen i skogen
Häftad bok. Stockholm : Bonnier. 1975.
Hyggligt skick. Slitet omslag som är ritat på.
Inrikes enhetsfrakt Sverige: 62 SEK- ISBN
- 9100390283
- Titel
- Med barnen i skogen
- Författare
- Pettersson, Rune
- Förlag
- Stockholm : Bonnier
- Utgivningsår
- 1975
- Språk
- Svenska
Stockholm : Bonnier 9100390283 -
 Inrikes enhetsfrakt Sverige: 62 SEK
Inrikes enhetsfrakt Sverige: 62 SEK- ISBN
- 9171335501
- Titel
- Fantastiska uppfinningar
- Författare
- Wood, Richard - Bergh, Birger - Back, Graham - Brandt, Bengt - Rosell, Göte
- Förlag
- Höganäs : Bra böcker
- Utgivningsår
- 1999
- Språk
- Svenska
Höganäs : Bra böcker 9171335501 -

Så funkar djur som kryper, krälar, simmar
Inbunden bok. Stockholm : Carlsen/if. 1986.
Hyggligt skick. Nötta och stötta hörn. Lite böjd.
Inrikes enhetsfrakt Sverige: 62 SEK- ISBN
- 9151044730
- Titel
- Så funkar djur som kryper, krälar, simmar
- Författare
- Kaufman, Joe - Van Couvering, John A. - Hammar, Birgitta - Staav, Roland
- Förlag
- Stockholm : Carlsen/if
- Utgivningsår
- 1986
- Språk
- Svenska
Stockholm : Carlsen/if 9151044730 -

IGCSE Physics
Häftad bok. Endorsed by Cambridge. 2 uppl. 2014.
ISBN 978034981870
Gott skick. CD finns. Använt skick.
Inrikes enhetsfrakt Sverige: 62 SEKEndorsed by Cambridge 2 978034981870 -
 Inrikes enhetsfrakt Sverige: 62 SEKStockholm : Prisma
Inrikes enhetsfrakt Sverige: 62 SEKStockholm : Prisma -

Guide to the Night Sky
Inbunden bok. Könemann. 2005.
ISBN 3833115858
Gott skick. Några understrykningar och anteckningar. Namndekal på baksidan.
Inrikes enhetsfrakt Sverige: 62 SEKKönemann 3833115858 -
 Inrikes enhetsfrakt Sverige: 62 SEKStevali 9783625120506
Inrikes enhetsfrakt Sverige: 62 SEKStevali 9783625120506 -

Dinosaurierna : Upptäckterna, arterna, underg...
Inbunden bok. Stevali. 1 uppl. 2013. 96 sidor.
Nära nyskick.
Inrikes enhetsfrakt Sverige: 62 SEK- ISBN
- 9783625120544
- Titel
- Dinosaurierna:Upptäckterna, arterna, undergången
- Förlag
- Stevali
- Utgivningsår
- 2013
- Omfång
- 96 sidor
- Bandtyp
- Inbunden
- Mått
- 237 x 294 mm Ryggbredd 14 mm
- Vikt
- 660 g
- Språk
- Svenska
- Baksidestext
- Vilka jätteödlor härskade under miljontals år över oceanerna och kontinenterna? Vad orsakade dinosauriernas, flygödlornas och havsreptilernas undergång? Vill du få svar på dessa och många andra frågor om livet under urtiden? Följ då med på en spännande resa i dinosauriernas värld: du får reda på hur livet på Jorden utvecklades och lär dig mer om dinosaurierna och deras förfäders utseende. Betrakta ett skelett av en Tyrannosaurus - träd in dinosauriernas värld och lär dig mer om till exempel Brachiosaurus, Spinosaurus och Triceratops. Sakkunniga texter och över 150 bilder åskådliggör och redogör för de viktigaste typerna och deras livsmiljöer - allt från stora köttätare såsom Allosaurus till mindre av typen Velociraptor. Lättfattliga texter, mängder av foton, grafik och illustrationer. Lämplig för barn från 10 år.
Stevali 1 9783625120544 -
 Inrikes enhetsfrakt Sverige: 62 SEK
Inrikes enhetsfrakt Sverige: 62 SEK- ISBN
- 9783625120490
- Titel
- Jorden : hav, kontinenter, universum
- Förlag
- Stevali
- Utgivningsår
- 2013
- Omfång
- 96 sidor
- Bandtyp
- Inbunden
- Mått
- 237 x 293 mm Ryggbredd 12 mm
- Vikt
- 660 g
- Språk
- Svenska
- Baksidestext
- Hur uppstår jordbävningar? Varför blixtrar det och dundrar det vid åskväder? Vad är egentligen växthuseffekten? Vill du få svar på dessa och många andra frågor om Jorden och omvärlden? Följ då med på en spännande resa och lär dig mer om geologi, geografi och miljö: du får kunskap om Jordens inre uppbyggnad och om kontinentaldriften. Du får veta hur en orkan uppstår och vad tidvatten beror på. sakkunniga texter och över 150 bilder åskådliggör och redogör för de vetenskapliga sakförhållandena gällande jordens inre och dess ytstruktur samt atmosfären och dess uppbyggnad. Lättfattliga texter, mängder av foton, grafik och illustrationer. Lämplig för barn från 10 år.
Stevali 1 9783625120490 -
 Inrikes enhetsfrakt Sverige: 62 SEKLTs Förlag
Inrikes enhetsfrakt Sverige: 62 SEKLTs Förlag
Your country and preferred language.
Select your country Select languageDenna webbplats använder cookies för att säkerställa att du får den bästa upplevelsen.
Stäng
Välkommen till Sveriges största bokhandel
Här finns så gott som allt som givits ut på den svenska bokmarknaden under de senaste hundra åren.
- Handla mot faktura och öppet köp i 21 dagar
- Oavsett vikt och antal artiklar handlar du till enhetsfrakt från samma säljare i samma kundvagn
















